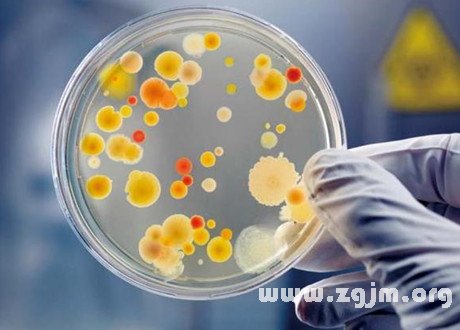

夢見髒東西是什麼意思?做夢夢見髒東西好不好?夢見髒東西有現實的影響和反應,也有夢者的主觀想像,請看下面由(周公解夢官網)小編幫你整理的夢見髒東西的詳細解說吧。
夢見髒東西,是好兆頭,身體會健康。
夢見你的衣服忽然沾上了髒髒的東西,這是吉利之夢,表示你的上司或是老闆會施恩於你,有可能是你長期得不到的東西他會送給你,或是很難解決的問是他也幫你解決了。
夢見好多髒水,有口舌之爭。
夢見喝髒水,如果是睡覺前沒喝水太渴了,到了夢裡,看到髒水就喝,為無意義之夢;如果不是則身體會有病。
夢見用髒水洗澡,親屬或朋友將會長逝。
夢見髒水噴泉,是不幸的兆頭。
夢見髒東西的案例分析
夢境描述:夢見自己去很偏遠的公廁去上廁所,一腳踩到屎上,太噁心了,上衣上不知怎么蹭到很多土噁心死了。
夢境解析:恭喜你,這是好兆頭,夢見髒東西,尤其是屎,代表你財運很旺喔!